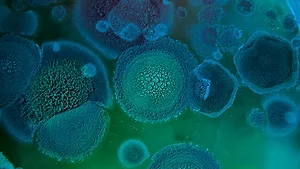
mold spores

Fentanyl: New Training to Decontaminate/Neutralize the Most Dangerous Contaminant
March 16, 2023
Fentanyl: New Training to Decontaminate/Neutralize the Most Dangerous Contaminant
March 16, 2023Milos Dimic/E+ via Getty Images
There is an epidemic running rampant across our country and there is a desperate need for qualified companies to safely be able to decontaminate and neutralize this clear and present danger. In order to do this you need the correct “Training, Tactics, Techniques and Tools that are necessary to properly contain, control, neutralize and remove this danger known as fentanyl,” says Jeff Jones of Microbial Warrior System of Decontamination.
The Dangers of Fentanyl
Fentanyl is a synthetic drug that is up to 50 times stronger than heroin and 100 times stronger than morphine. There are two categories of fentanyl: pharmaceutical and illicitly manufactured. Both are considered synthetic opioids. Pharmaceutical fentanyl is prescribed by doctors to treat severe pain, typically after surgery or for advanced stages of cancer. Under the supervision of a licensed medical professional, fentanyl has a legitimate medical use. Patients prescribed fentanyl should be monitored for potential misuse or abuse.
Illicitly manufactured fentanyl (IMF) is available on the drug market in different forms, including liquid and powder. In powdered from, fentanyl looks just like many other drugs and is commonly mixed with other drugs like heroin, cocaine, and methamphetamine and has been made to resemble other prescription opioids. Fentanyl-laced drugs are very dangerous, and many people may be unaware that their drugs are laced with fentanyl. In its liquid form IMF can be found in nasal sprays, eye drops and could be dropped onto paper or small candies.
According to the United States Drug Enforcement Administration (DEA), it only takes 2 milligrams of fentanyl to be lethal depending on a person’s body size, tolerance and past usage. DEA analysis have found counterfeit pills ranging from .02 to .51 milligrams of fentanyl per tablet, more than twice the lethal dose.
- 42% of pills tested for fentanyl contained at least 2 mg of fentanyl which is considered a potential lethal dose.
- Drug trafficking organizations typically distribute fentanyl by the kilogram. One kilogram of fentanyl has the potential to kill 500,000 people.
According to the Centers for Disease Control and Prevention (CDC), synthetic opioids like fentanyl are the primary source for overdose death in the United States. Over 150 people die daily from overdoses related to synthetic opioids like fentanyl. Declared a national emergency and a clear and present danger to the security of the United States of America by the President, there is now an answer and solution to the fentanyl overdose epidemic, one of the most dangerous contaminants mankind has ever faced.
The Certified High Risk High Level Decontamination Specialist Program
The answer and solution has come about by a Certified High Risk High Level Decontamination Specialist training program that teaches the decontamination and neutralization of this deadly contaminant. This program was created by Jeff Jones, a Specialist in Counterterrorism, former US Army Soldier, Former SWAT team leader, and the youngest person to attend the FBI Academy in Quantico, Virginia. Jeff is a Certified Bio-Forensic Restoration Specialist as well as a Certified Forensic Operator with over 50 years of field experience in Forensic Restoration.
These findings are of vast importance because it can in turn save the lives of everyone who potentially interacts with this drug knowingly or unknowingly, especially first responders and those in the restoration and remediation industry who are in the field working to mitigate this deadly contaminant first-hand each and every day. As of last year, 2022, fentanyl has taken over 100,000 American lives. That is more than firearm deaths at 30,000 and automobile deaths at over 40,000 combined.
The lifesaving program, Certified High Risk High Level Decontamination Specialist, is built on following proper protocols and procedures that have been developed over 2 years of strenuous testing, re-testing, and testing again of every product to make sure it was a top-tier standard becoming a fail-proof system. The product that the program was built upon has received the stamp of approval by top scientists that the government and U.S. military officials rely on for their decontamination purposes.
Looking for a reprint of this article?
From high-res PDFs to custom plaques, order your copy today!
Creator Jeff Jones felt this was an important step to help ensure the quality of the lifesaving training program and align with his prime directive of safety, for both the team of operators and all future occupants of any space that may be contaminated. As Jeff says, “I will be the first one in, and the last one out. I will not surrender an environment until I’m comfortable with someone opening a daycare in it the very next day.”
Program Objectives
There are 4 objectives or strategies that are key when professionals are called in to contain dangerous micro-environments to ensure their safety and that of others. Contain, Control, Neutralize and Remove. The same strategy used when Jeff was working with SWAT. The Certified High Risk High Level Decontamination Specialist program has trainees make a tactical incursion into the micro-environment, meaning they will strategically plan what’s going to happen (tactical) and then attack the situation (incursion).
There are two tiers of the program: one for those who will be doing the remediation work, and another for law enforcement and first responders. The goal is to arm trainees with training, tactics, techniques and tools, most importantly understanding that without training, tactics and techniques, the tools are useless.
“You won’t get anywhere in this life with a passive mindset, you’ve got to have a warrior’s attitude. What we’re doing is making the world a better place for the elderly, children, for people that can’t defend themselves.” –Jeff Jones
In Restoration & Remediation’s first episode of the R&R Restoration Report, we share even more on what this lifesaving training entails.